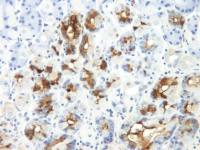
TFF-2 antibody

相关产品推荐更多 >
万千商家帮你免费找货
0 人在求购买到急需产品
- 详细信息
- 文献和实验
- 技术资料
- 免疫原:
ApoA5 antibody was raised against a 15 amino acid synthetic peptide near the carboxy terminus of chicken ApoA5.The immunogen is located within the last 50 amino acids of ApoA5.
- 亚型:
IgG
- 形态:
Liquid
- 保存条件:
Store as concentrated solution. Centrifuge briefly prior to opening vial. For short-term storage (1-2 weeks), store at 4ºC. For long-term storage, aliquot and store at -20ºC or below. Avoid multiple freeze-thaw cycles.
- 克隆性:
Polyclonal
- 标记物:
Unconjugated
- 适应物种:
Human, Chicken
- 保质期:
12 months from the shipping date of the product.
- 抗原来源:
Chicken
- 目录编号:
GTX17120
- 级别:
Primary Antibodies
- 库存:
Available
- 供应商:
GeneTex
- 宿主:
Rabbit
- 应用范围:
WB, ELISA
- 浓度:
1 mg/ml (Please refer to the vial label for the specific concentration.)
- 靶点:
Apolipoprotein A5
- 抗体英文名:
Apolipoprotein A5 antibody
- 抗体名:
Apolipoprotein A5 抗体
- 规格:
100 μg
WB analysis of human liver tissue lysate using GTX17120 Apolipoprotein A5 antibody.
Working concentration : 1 μg/ml
风险提示:丁香通仅作为第三方平台,为商家信息发布提供平台空间。用户咨询产品时请注意保护个人信息及财产安全,合理判断,谨慎选购商品,商家和用户对交易行为负责。对于医疗器械类产品,请先查证核实企业经营资质和医疗器械产品注册证情况。
文献和实验上海西唐生物科技有限公司 021-55229872, 65333639 www.westang.com 人载脂蛋白A5 (APO A5)ELISA 试剂盒 ( 用于血清、血浆、细胞培养上清液和其它生物体液内 ) 原理 本实验采用双抗体夹心 ABC-ELISA 法。用抗人 APO A5 单抗包被于酶标板上,标准品和样品中的 APO A5与单抗结合,加入生物素化的抗人 APO
人整合素a5b3(Integrin a5b3)ELISA试剂盒 说明书
第一抗体工作液( Biotinylated Antibody ) 12ml 终止液 (Stop Solution ) 12ml 准备试剂与收集血样 1. 收集标本:血清、血浆(EDTA )、细胞培养上清液、组织匀浆等尽早检测, 2-8 ℃ 保存48 小时;更长时间须
secondary antibody review -- data from 99 publications
cytometry used as a control to detect cell responses targeted antigen 7 Alexa Fluor 488 7 Cy3 8 goat IgG Alexa Fluor 488 1:2000 detect antibody binding in human embryonic kidney 293T cells Invitrogen 9 donkey
技术资料暂无技术资料 索取技术资料